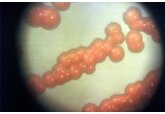

Доказано повышение уровня океана из-за атмосферных рек
Communications Earth & Environment: уровень моря повысится из-за рек в атмосфере
Группа климатологов из Национального центра атмосферных исследований NSF, Лаборатории климата и глобальной динамики, Техасского университета A&M и Университета штата Пенсильвания обнаружила доказательства связи значительного повышения уровня океана с деятельностью атмосферных рек (АР), формирующихся в Тихом океане и достигающих побережья Северной Америки. Их исследование было опубликовано в журнале Communications Earth & Environment.
Атмосферные реки (АР) — это мощные потоки водяного пара в атмосфере, которые могут переносить огромное количество осадков и вызывать сильные ветры. С учетом глобального потепления исследователи прогнозируют, что частота АР увеличится и они будут сопровождаться более интенсивными осадками и ветрами. Помимо этого исследование показало, что АР также приведут к значительному повышению уровня моря на побережье, где они достигают суши.
Для прогнозирования будущего уровня океана ученые использовали данные о предыдущих атмосферных реках, которые затронули западное побережье США, включая Калифорнию, Орегон и Вашингтон. Они создали компьютерные модели, учитывающие изменение климата, такие как потепление воздуха и воды, чтобы предсказать, насколько сильно поднимется уровень океана во время будущих АР.
Результаты моделирования показали, что уровень океана может повыситься на 200 процентов по сравнению с прошлыми показателями во время АР. Это особенно тревожно для прибрежных сообществ Калифорнии, так как такие резкие изменения могут привести к катастрофическим наводнениям, учитывая количество осадков, связанное с атмосферными реками.
Моделирование также выявило, что подъем уровня океана будет варьироваться в разных частях побережья Калифорнии. На юге штата, например в районе Лос-Анджелеса, ожидается больше АР с большим количеством осадков и более сильными ветрами по сравнению с северными регионами, что приведет к более высокому повышению уровня океана в этих районах.
Исследование подчеркивает необходимость учитывать риски, связанные с атмосферными реками и повышением уровня океана, при планировании мер по защите побережья. Эти прогнозы требуют разработки стратегий для смягчения последствий изменений климата и защиты уязвимых прибрежных сообществ.
Communications Earth & Environment